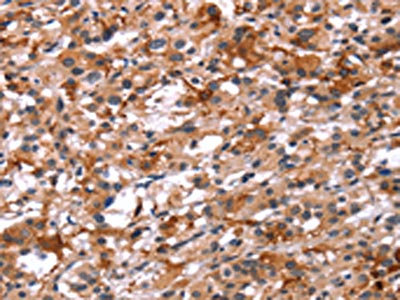

GCGR Antibody
-
中文名稱:GCGR兔多克隆抗體
-
貨號:CSB-PA222690
-
規格:¥1100
-
圖片:
-
The image on the left is immunohistochemistry of paraffin-embedded Human thyroid cancer tissue using CSB-PA222690(GCGR Antibody) at dilution 1/40, on the right is treated with synthetic peptide. (Original magnification: ×200)
-
Gel: 8%SDS-PAGE, Lysate: 50 μg, Lane: 293T cells, Primary antibody: CSB-PA222690(GCGR Antibody) at dilution 1/200, Secondary antibody: Goat anti rabbit IgG at 1/8000 dilution, Exposure time: 30 seconds
-
-
其他:
產品詳情
-
Uniprot No.:
-
基因名:
-
別名:GCGR; Glucagon receptor; GL-R
-
宿主:Rabbit
-
反應種屬:Human,Mouse,Rat
-
免疫原:Synthetic peptide of Human GCGR
-
免疫原種屬:Homo sapiens (Human)
-
標記方式:Non-conjugated
-
抗體亞型:IgG
-
純化方式:Antigen affinity purification
-
濃度:It differs from different batches. Please contact us to confirm it.
-
保存緩沖液:-20°C, pH7.4 PBS, 0.05% NaN3, 40% Glycerol
-
產品提供形式:Liquid
-
應用范圍:ELISA,WB,IHC
-
推薦稀釋比:
Application Recommended Dilution ELISA 1:1000-1:2000 WB 1:200-1:1000 IHC 1:50-1:200 -
Protocols:
-
儲存條件:Upon receipt, store at -20°C or -80°C. Avoid repeated freeze.
-
貨期:Basically, we can dispatch the products out in 1-3 working days after receiving your orders. Delivery time maybe differs from different purchasing way or location, please kindly consult your local distributors for specific delivery time.
-
用途:For Research Use Only. Not for use in diagnostic or therapeutic procedures.
相關產品
靶點詳情
-
功能:G-protein coupled receptor for glucagon that plays a central role in the regulation of blood glucose levels and glucose homeostasis. Regulates the rate of hepatic glucose production by promoting glycogen hydrolysis and gluconeogenesis. Plays an important role in mediating the responses to fasting. Ligand binding causes a conformation change that triggers signaling via guanine nucleotide-binding proteins (G proteins) and modulates the activity of down-stream effectors, such as adenylate cyclase. Promotes activation of adenylate cyclase. Besides, plays a role in signaling via a phosphatidylinositol-calcium second messenger system.
-
基因功能參考文獻:
- 3.0 A-resolution crystal structure of the full-length human glucagon receptor (GCGR) in complex with a glucagon analogue and partial agonist, NNC1702 PMID: 29300013
- work toward the mapping of interactions between the polypeptide hormone glucagon and the glucagon receptor PMID: 28508109
- 3.0 A crystal structure of full-length GCGR containing both the extracellular domain and transmembrane domain in an inactive conformation PMID: 28514451
- This work suggests that RAMP2 may modify the agonist activity and trafficking of the GCGR, with potential relevance to production of new peptide analogs with selective agonist activities. PMID: 28586439
- Data suggest that GCGR activation proceeds via a mechanism in which transmembrane helix 6 (TM6) is held in an inactive conformation by a conserved polar core and a hydrophobic lock (involving intracellular loop 3, IC3); mutations in the corresponding polar core of GCGR disrupt these inhibitory elements, allow TM6 to swing outward, and induce constitutive G protein signaling. PMID: 28356352
- The activation of the GCGR is characterized by the outward movement of the intracellular side of helix VI. In the active state of the GCGR, the Arg173(2.46)-Ser350(6.41) and Glu245(3.50)-Thr351(6.42) hydrogen bonds break, and the chi1 rotamer of Phe322(5.54) changes from perpendicular to parallel to helix VI. PMID: 27094704
- In the glucagon receptor (GCGR) and glucagon-like peptide-1 receptor (GLP-1R), the extracellular domain is required for signaling even when the hormone is covalently linked to the transmembrane domain. PMID: 27226600
- 2.5 A crystal structure of human GCGR in complex with the antagonist MK-0893, which is found to bind to an allosteric site outside the seven transmembrane helical bundle in a position between TM6 and TM7 extending into the lipid bilayer PMID: 27111510
- Molecular dynamics and disulfide crosslinking studies suggest that apo-GCGR can adopt both an open and closed conformation associated with extensive contacts between the ECD and 7TM domain. Glucagon binds to GCGR by a conformational selection mechanism. PMID: 26227798
- glucagon cell adenomatosis with GCGR germline mutations seems to follow an autosomal-recessive trait. PMID: 25695890
- Using a real-time time-resolved FRET-based internalization assay, we show that GLP-1R, GIPR, and GCGR internalize with differential properties PMID: 25451942
- crystal structure of the seven transmembrane helical domain of human GCGR at 3.4 A resolution, and a hybrid model of glucagon bound to GCGR to understand the molecular recognition of the receptor for its native ligand PMID: 23863937
- Letter/Case Report: nonfunctional glucagon cell adenomatosis with no detectable glucagon receptor mutations. PMID: 23407487
- GRA1 is a potent glucagon receptor antagonist with strong antihyperglycemic efficacy in preclinical models and prominent effects on hepatic gene-expression related to amino acid metabolism PMID: 23185367
- F22, V23, M27, and D15 of GCGR are the most important residues for glucagon binding. PMID: 22893257
- in addition to activation of the classic cAMP/protein kinase A (PKA) pathway, activation of GCGR also induced beta-catenin stabilization and activated beta-catenin-mediated transcription PMID: 22438981
- analysis of glucagon receptor antagonists with reduced molecular weight and lipophilicity PMID: 22119466
- The P86S mutant GCGR shows abnormal receptor internalization & calcium mobilization, & causes apoptosis. It cases Mahvash disease (hyperglucagonemia, hypoglycemia, pancreatic neuroendocrine tumors). PMID: 21680267
- substituted cysteine accessibility method and 3D-molecular modeling to study the N-terminal domain; results showed that Asp(63), Arg(116), and Lys(98) are essential for the receptor structure and/or ligand binding PMID: 20647307
- The [Ca2+] response is induced by glucagon mainly via the coupling of GCGR to the Galphaq/11 and Galphai/o proteins. PMID: 19903011
- The Gly40Ser polymorphism of the GCGR gene is associated with higher risk of hypertension and with enhanced proximal tubular sodium reabsorption. PMID: 11692154
- Gly40Ser mutation in the glucagon receptor gene is not associated with type 2 diabetes in a Brazilian population, but a reduction of insulin secretion was observed in Gly40Ser carriers. PMID: 11961492
- Three distinct epitopes on the extracellular face of the glucagon receptor determine specificity for the glucagon amino terminus PMID: 12724331
- Expression of peroxisome proliferator-activated receptor gamma coactivator 1alpha (PGC-1alpha), known to be upregulated in the liver by fasting, was found to abolish the cAMP-dependent downregulation of glucagon receptor mRNA expression in vitro. PMID: 17374560
顯示更多
收起更多
-
亞細胞定位:Cell membrane; Multi-pass membrane protein.
-
蛋白家族:G-protein coupled receptor 2 family
-
數據庫鏈接:
Most popular with customers
-
-
-
-
-
-
-
VDAC1 Recombinant Monoclonal Antibody
Applications: ELISA, WB, IHC
Species Reactivity: Human, Mouse, Rat
-
VCP Recombinant Monoclonal Antibody
Applications: ELISA, WB, IHC, IF, IP
Species Reactivity: Human, Rat